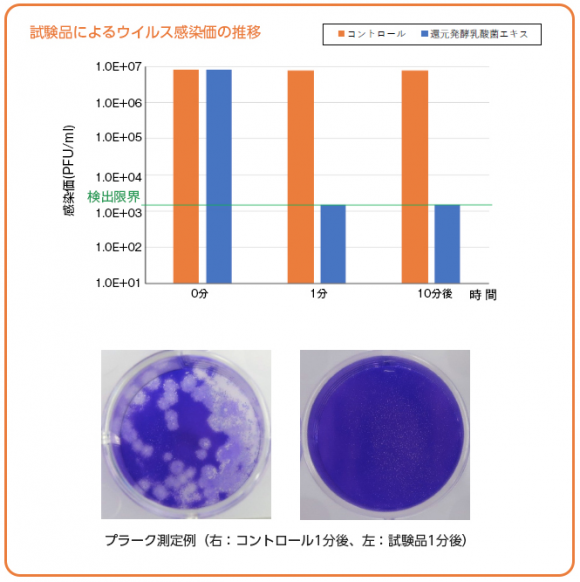
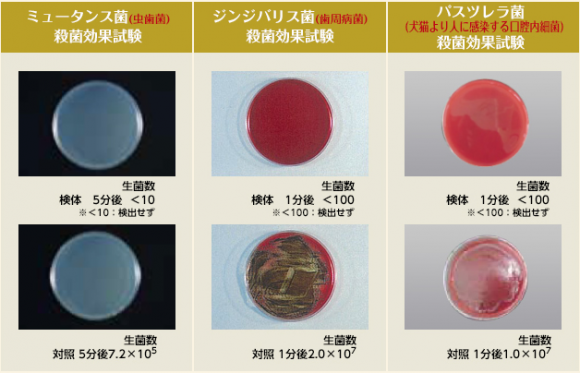

製品データ
| 原料・成分 | 乳酸菌 |
| 種類 | 死菌 |
| 原産国(最終加工国) | 日本 |
詳細情報
水素パワーで生まれた悪玉菌・ウィルスクレンズ乳酸菌


還元発酵乳酸菌は、12種乳酸菌の複合培養時に、水素・海洋深層水を最適な濃度でブレンドし、熟成発酵させたところに、梅エキスを添加し生成される。体内浄化を目指して、組み合わせる素材を吟味し、同社の豊富な知見や健康への基本理念をベースに4つの素材を組み合わせ辿り着いた。
(特願2019-195717、商標登録第6182055号、商標登録第622549号)

重要なポイントは、4つの素材の配合比だ。同社では、乳酸菌発酵エキスのポテンシャルを最大限に引き出すべく、その配合割合を何度も変更。約6年間の試行錯誤を経て、黄金比を割り出し、高い機能性を有する乳酸菌複合素材としてその開発に成功した。
戦う還元発酵乳酸菌®の働き方
近年はやっているコロナウイルス、インフルエンザ、ヒト免疫不全ウイルス(HIVウイルス)などは「エンベロープ」という薄い膜でできている。この薄い膜が破られると、ウイルスは一瞬で死滅する。

このエンベロープ膜を持つ新型コロナウイルス(SARS-CoV-2)を還元発酵乳酸菌エキスは、速やかに不活化することが判明した。新型コロナウイルスに対して、還元発酵乳酸菌エキスは8.25×106 PFU/mlから1分後で<1.50×103 PFU/ml(減少率>99.981%)と検出限界まで感染価が減少した。

エンベロープ膜を持つ豚コロナウイルスに対し、還元発酵乳酸菌エキスは、30分以内に99.9%不活性化が認められている。

このエンベロープ膜を持つ新型コロナウイルス(SARS-CoV-2)を還元発酵乳酸菌エキスは、速やかに不活化することが判明した。新型コロナウイルスに対して、還元発酵乳酸菌エキスは8.25×106 PFU/mlから1分後で<1.50×103 PFU/ml(減少率>99.981%)と検出限界まで感染価が減少した。
エンベロープ膜を持つ豚コロナウイルスに対し、還元発酵乳酸菌エキスは、30分以内に99.9%不活性化が認められている。
豚コロナウイルス不活性化試験に加えて、インフルエンザウイルス、ネコカリシウイルス(ノロウイルス代替)への不活性化作用も確認されている。




悪玉菌ケアでアプローチしてもするインナービューティー素材

もっとも、活況の乳酸菌市場に後発で乗り込む以上、強みや独自性がなければ埋もれてしまう。そこで同社が着目したのが、悪玉菌クレンズ及び抗糖化というアプローチだ。4つの組み合わせの中に水素や海洋深層水が含まれている理由もなんとなく想像できるだろう。
腸内フローラへの訴求と言えば、プロバイオティックス(乳酸菌・ビフィズス菌)やプレバイオティックス(オリゴ糖)等の摂取による善玉菌増殖に主眼が置かれがち。善玉菌が増えることで腸内環境が改善されるというロジックだ。
「体内に良いものが増える=体に良い」は訴求としては分かりやすい。だが、同社は、内面美容の観点から、乳酸菌へのアプローチに加え、乳酸菌発酵エキス・抗菌ペプチド活性化による悪玉菌クレンズ(腸内・口腔ケア)・抗糖化にその活路を見出した。
実験データ
試験では、悪玉菌への高い消去能、抗糖化・抗酸化・美肌ケアを確認した。虫歯菌のミュータンス菌、および歯周病菌のジンジバリス菌の殺菌効果試験では、ミュータンス菌が5分後、ジンジバリス菌では1分後に検出されなくなった。また、犬猫とのキスにより口移し感染するパスツレラ菌の殺菌効果試験でも同素材は1分後に不検出となった。(図表参照)。

胃がんのリスク要因として知られるピロリ菌の殺菌効果試験では5分後に不検出となった。大腸内の2大悪玉菌である「黄色ブドウ球菌」「ウェルシュ菌」の殺菌効果試験では前者が5分後、後者で1分後に不検出となった。更に補足的に善玉菌へ影響確認試験も行われており、5分後には善玉菌を増殖させる事が確認された。

他にも同素材を希釈したもので抗酸化・抗糖化・美肌ケアへの影響についての外部試験を実施。図表のような結果が得られている。


理屈としては、腸内で9割発生すると言われる活性酸素を生み出す主因「悪玉菌」を減らす事による抗酸化。加えて、蓄積すると老化や病気の原因となるAGEs生成を抑制する事による抗糖化――。老化や病気の2大要因である酸化・糖化への対策を軸に、どこまでの機能性を示せるかが、同素材の差別化要因となる。
黄金比率により、乳酸菌発酵エキスのポテンシャルが大きく引き出された同素材は、乳酸菌共生培養としては高水準の「1000億個/g以上の乳酸菌(死菌体)」を含有。機能性の高い乳酸菌として大いに期待できるスペックを有する事が各種外部試験にて確認されている。
血糖値上昇抑制
試験方法:αグルコシダーゼ阻害活性試験(血糖値上昇抑制)

同品を純水で100倍に希釈しフィルターでろ過したものを原液とした。原液および原液を純水で10倍、100倍に希釈した液を測定試料とした。各マイクロチューブに試験溶液を加え攪拌後に酵素溶液、リン酸ナトリウム緩衝液を指定量入れ指定温度、指定時間プレインキュベート(プレコントロール)した後、指定量の基質溶液を加えて攪拌後、指定温度、指定時間インキュベート(コントロール)した。αグルコシダーゼ阻害活性率を吸光度の変化量より算出。
抗糖化(AGEs中間反応体の架橋切断)
試験方法:AGEs架橋切断率試験

同品を純水で100倍希釈しフィルターでろ過したものを原液とした。原液および原液を純水で10倍、100倍に希釈した液を試料溶液とした。測定は試験溶液、1-フェニル-1,2-プロパンジオン溶液およびメタノールを混合し反応溶液とした。反応溶液中の1-フェニル-1,2-プロパンジオンがすべて安息香酸に分解された場合のAGEs架橋切断率を100%として算出。
抗酸化
試験方法:抗酸化姓(SOD様活性)試験

同品を純水で100倍に希釈しフィルターでろ過したものを原液とした。原液および原液をSOD Assay Kit-WST(同仁化学社製)付属の暖衝液で10倍、100倍に希釈した液について、SOD Assay Kit-WSTを用いて阻害率を算出。
ヒアルロン酸分解酵素の抑制
試験方法:ヒアルロニダーゼ阻害活性測定

同品を純水で100倍希釈しフィルターでろ過したものを原液とした。原液および原液を純水で10倍、100倍に希釈した液を試料溶液とした。測定は酵素溶液、基質溶液、酵素活性剤、発色液などを用いて行った。測定試料を添加した際のヒアルロニダーゼ阻害活性率を吸光度の変化量より算出。
まとめ
悪玉菌へのアプローチは、試験管内にて目論見通りの結果となり、同素材が高い機能性を有する乳酸菌である事が実証されたといえる。今後の更なる研究にも期待がかかるが、12種乳酸菌の共棲培養という環境下、1グラム当たり1000億個以上の乳酸菌数含有に代表される同素材のポテンシャルが、活況の乳酸菌市場の中でも独自ポジションを確立する可能性が高いといえそうだ。
ユニークで付加価値の高い乳酸菌としてサプリメント、飲料口腔ケア関連で活用
パウダーとして提供される同素材は、低温のフリーズドライにて丁寧に加工され、開発プロセスで引き出されたポテンシャルをしっかりとキープ。高品質で、安心して利用できる。
想定される用途は、サプリメントや飲料、更に口腔ケアとの関連でガムやチュアブル等での活用も面白いかもしれない。昨今の食品メーカーの機能性へのニーズの高さからも、ユニークで付加価値の高い乳酸菌原料として、多くの引き合いが期待できそうだ。
口腔内、腸内をダブルでケアするというアプローチは、まさに入り口・内部での「悪玉菌対策」であり、「善玉菌増殖のみ」へのアプローチよりもむしろ目的がストレートに伝わり易いともいえる。炭や水素関連で実績を積み上げてきた同社が乳酸菌というのは異色にも映るが、「抗酸化」や「抗糖化」をキーワードとしてみれば納得もいく。第三者機関によるエビデンスもしっかりと揃えており、飽和気味の乳酸菌市場でも十分に存在感を示していけそうだ。

動画再生はこちら
想定される用途は、サプリメントや飲料、更に口腔ケアとの関連でガムやチュアブル等での活用も面白いかもしれない。昨今の食品メーカーの機能性へのニーズの高さからも、ユニークで付加価値の高い乳酸菌原料として、多くの引き合いが期待できそうだ。
口腔内、腸内をダブルでケアするというアプローチは、まさに入り口・内部での「悪玉菌対策」であり、「善玉菌増殖のみ」へのアプローチよりもむしろ目的がストレートに伝わり易いともいえる。炭や水素関連で実績を積み上げてきた同社が乳酸菌というのは異色にも映るが、「抗酸化」や「抗糖化」をキーワードとしてみれば納得もいく。第三者機関によるエビデンスもしっかりと揃えており、飽和気味の乳酸菌市場でも十分に存在感を示していけそうだ。

動画再生はこちら
創業者 横山功夫氏に聞く
悪玉菌ケアというアプローチによる腸内ケア

還元ミネラル水素パウダー™と機能性食用炭™を中心に歩み続けて来た弊社ですが、実は創業間もない頃に、歯科医師の研究会で長年口腔ケアに活用されている「乳酸菌発酵エキス」メーカーの社長さんとのご縁ができ、いつかコラボレーションを実現したいと研究を続けて参りました。還元発酵乳酸菌はその意味で足掛け6年で生まれた原料といえます。
乳酸菌共棲培養の発酵エキスに水素、海洋深層水を最適比率にてブレンドする事で乳酸菌数が急速に増大すると共に、抗菌ペプチドが多量に生み出される事を発見しました。更に還元発酵下で生成された抗菌ペプチドに梅エキスを加える事でパワーが大きく増強される事が分かりました。
還元発酵乳酸菌では、腸内・口腔内のケアを、善玉菌の増殖のみへのアプローチではなく、悪玉菌ケアという視点も取り入れました。ここが一番の特徴となります。インナービューティー(内面美容)への観点から、抗糖化・抗酸化・美肌ケアへの影響確認試験を実施したところ、大変良好な結果が得られました。さらに善玉菌増殖も確認され、乳酸菌原料としてユニークな存在になると考えています。
今後更なる研究を積み重ね、弊社が目指す「人への抗酸化・抗糖化」というテーマを追求して行きたいと考えております。






